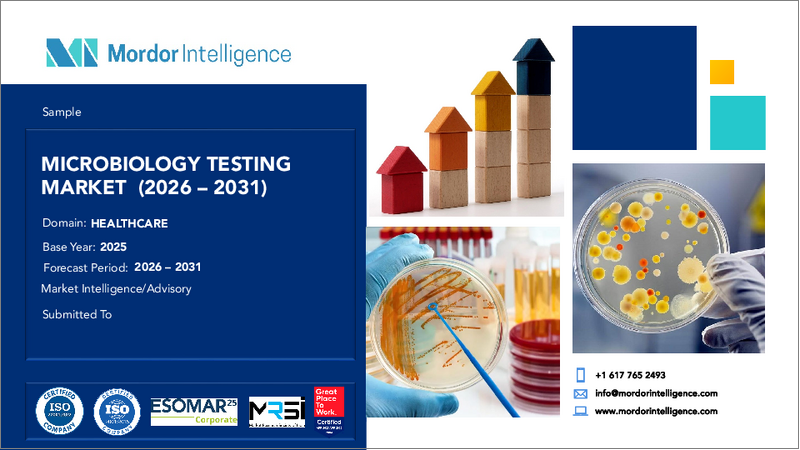
表紙:微生物検査:市場シェア分析、産業動向、統計、成長予測(2025年~2030年)

|
|
市場調査レポート
商品コード
1851228
微生物検査:市場シェア分析、産業動向、統計、成長予測(2025年~2030年)Microbiology Testing - Market Share Analysis, Industry Trends & Statistics, Growth Forecasts (2025 - 2030) |
||||||
カスタマイズ可能
適宜更新あり
|
|||||||
| 微生物検査:市場シェア分析、産業動向、統計、成長予測(2025年~2030年) |
|
出版日: 2025年07月24日
発行: Mordor Intelligence
ページ情報: 英文 112 Pages
納期: 2~3営業日
|
概要
微生物検査市場規模は2025年に61億4,000万米ドルに達し、CAGR 9.22%を記録し、2030年には95億9,000万米ドルにまで収益を引き上げると予測されています。

より迅速な病原体同定に対する臨床上の需要、抗菌薬耐性の広がり、検査室の自動化の加速が、最も強力な成長の触媒です。各国政府は医薬品、食品、パーソナルケアのサプライチェーンに対する規制監督を強化しており、日常的な微生物品質管理の頻度と範囲を引き上げています。同時に、AIを活用した質量分析計や分子プラットフォームは納期を短縮し、病院は数日ではなく数時間以内に標的治療を開始できるようになります。2桁の欠員率に直面している検査室は、慢性的な人員不足に対する最も現実的な解決策として、検査室の全自動化を考えています。迅速診断に接続性、分析、遠隔サポート機能を組み合わせることができるメーカーは、微生物検査市場における将来の入札で不釣り合いなシェアを獲得すると思われます。
世界の微生物検査市場の動向と洞察
診断技術と自動化の進歩
ラボの自動化は、AIガイド付きイメージングシステムとロボットの組み合わせによって微生物学のワークフローを再構築します。MALDI-TOFのような質量分析プラットフォームは、かつては2日を要した手作業に代わって、数分で生物種レベルの同定が可能な機械学習モデルを統合しています。完全に自動化された「ダークラボ」は、人員不足やCOVID-19のような危機の際にも、消灯シフトを操作して必要不可欠な検査を継続します。病院情報システムとの相互運用性により、シームレスなデータフローが可能となり、感染管理ダッシュボードや抗菌薬管理アラートをサポートします。ハードウェア、試薬、クラウドベースのアナリティクスをサービス契約にバンドルするベンダーは、所有コストを下げながらアップタイムを改善し、微生物検査市場でのオファーの魅力を高めています。
感染症の増加と抗菌薬耐性
薬剤耐性病原体の増加により、臨床医は患者の入院から重要な時間内に同定と耐性マーカーを提供できる培養に依存しない検査を採用する必要に迫られています。米国だけでもヘルスケア関連感染で年間200億米ドル以上のコストがかかっており、広域抗生物質の過剰使用を防ぐ迅速診断の導入が病院へのプレッシャーとなっています。蚊が媒介する感染症が気候の影響を受けて拡大する中、共存するアルボウイルスを鑑別できる分子パネルに対する基本的な需要が高まっています。標的治療が死亡率と入院期間を低下させるという証拠が、1時間のマルチプレックスPCRアッセイへの関心を高めています。政策立案者はタイムリーな微生物学的データに依存する監視ネットワークに資金を振り向け、その結果、微生物検査市場全体の高度システムの設置ベースが拡大します。
高い設備投資と運用コスト
検査室自動化システムには、1施設あたり200万米ドルから500万米ドルの初期投資が必要であり、小規模の地域病院や独立系検査室がクリアするのに苦労するハードルです。MALDI-TOF装置は検査ごとのコストを削減するが、それでもハードウェアと年間データベースライセンス料に50万米ドル以上を要求します。分子試薬パックの価格は1パネルあたり100-200米ドルで、培養法の10-20米ドルの消耗品を凌駕します。施設は、管理された環境室、冗長電源、特殊なITインフラにも予算を割かなければならないです。数量ベースのディスカウントがなければ、新興市場のラボの多くは次世代プラットフォームから締め出されたままとなり、市場セグメンテーション市場の参入可能なセグメントを狭めてしまいます。
セグメント分析
臨床診断薬は2024年の売上高の31.34%を占めたが、これは病院が即日病原体を確認してヘルスケア関連感染を抑制することを優先していることを反映しています。医薬品品質管理は、cGMP規則により無菌保証試験後にのみバッチリリースが義務付けられているため、金額で2位となりました。飲食品加工業者は、複数のチェックポイントでの病原体スクリーニングを義務付ける危害分析重要管理点(Hazard Analysis and Critical Control Point)基準を採用しました。環境モニタリングは、より厳格な廃水および修復規則により、着実に拡大しています。
化粧品検査はCAGR 11.45%と最も急速に拡大したが、これはEU規則1223/2009が安全性書類を義務付けており、防腐剤の少ない「クリーンラベル」処方へのシフトが汚染リスクを高めているためです。ブランドが植物由来成分を推進するにつれて、微生物のハードルは上昇し、チャレンジテストや防腐剤有効性試験の需要を促進しています。パーソナルケア微生物学に特化した受託ラボが新たなアウトソーシング契約を獲得し、微生物検査市場規模内での足跡を拡大。
試薬と消耗品は2024年の支出額の73.56%を占める。これは培養や分子生物学的検査を行うたびに培地、パネル、ディスク、カートリッジが消費され、安定した補充サイクルが確保されるためです。COVID-19危機の際の在庫切れの恐怖は、調達チームにサプライヤーの多様化と在庫バッファーの構築を確信させました。マルチプレックス呼吸器パネル、発色性培地、ASTカードは、微生物検査市場のメーカーにとってキャッシュフロー基盤を支える主な収益源であり続けています。
検査室がワークフロー時間を短縮するハイスループットのストリーカー、インキュベーター、質量分析計にアップグレードするにつれて、機器の売上は11.89%のCAGRで増加します。2024年だけで550台以上のVITEK MS PRIMEシステムが導入されたが、これは精度を犠牲にすることなく同定を迅速化したいという需要を反映しています。LISミドルウェアと組み合わせた自動感受性プラットフォームは、リアルタイムの報告と抗菌薬管理に関する通知を可能にします。サービス契約とソフトウェア・ライセンスは、ハードウェア販売に年金層を追加し、生涯顧客価値を高めます。
地域分析
北米は2024年の売上高の42.43%を占め、高度な病院インフラ、感染制御ガイドラインの義務化、新規診断薬に対する明確な規制経路に支えられています。食品安全近代化法は広範な病原体モニタリングを義務付けており、食品加工業者やリファレンスラボの需要を刺激しています。迅速診断を償還する連邦政府のプログラムは、プレミアム分子パネルのビジネスケースを強化し、この地域における微生物検査市場のリーダーシップを強化しています。
欧州は第2位であり、食品については規則2073/2005の下で厳格な基準が維持され、医薬品についてはcGMPの枠組みが十分に強化されています。ドイツ、フランス、北欧諸国が設置された自動化ラインの大部分を占め、規制1223/2009により化粧品検査ラボは欧州全域で多忙を極めています。欧州疾病予防管理センター(European Centre for Disease Prevention and Control)を通じた共同サーベイランスは、アウトブレイク対応の調和を図り、間接的に先進的検査システムの汎地域的な導入を促しています。
アジア太平洋地域は、中国、インド、東南アジア諸国が公衆衛生の回復力を支える検査ネットワークに資本を投入しているため、CAGR10.54%で最も急成長している地域です。生物製剤とワクチン製造の大規模な拡大により、環境モニタリングと無菌試験の安定したニーズが生まれます。POC(ポイント・オブ・ケア)分子検査装置をいち早く導入した日本の病院は、迅速診断の業務上の利点を紹介し、地域の同業機関に追随を促します。インフラが整備されるにつれて、以前は十分なサービスを受けられなかった地方市場が開拓され、地域全体で対応可能な微生物検査市場規模が拡大します。
その他の特典:
- エクセル形式の市場予測(ME)シート
- 3ヶ月間のアナリストサポート
よくあるご質問
目次
第1章 イントロダクション
- 調査の前提条件と市場の定義
- 調査範囲
第2章 調査手法
第3章 エグゼクティブサマリー
第4章 市場情勢
- 市場概要
- 市場促進要因
- 診断技術と自動化の進歩
- 感染症の増加と抗菌薬耐性
- 公的・民間ヘルスケア資金の拡大
- 迅速検査およびポイントオブケア検査ソリューションに対する需要の高まり
- 製品の安全性と品質に関する厳しい規制基準
- 医薬品、食品、環境検査における用途の多様化
- 市場抑制要因
- 高い設備投資と運用コスト
- 新規検査の償還と価格設定の課題
- 熟練した臨床検査技師の不足
- 重要試薬・消耗品のサプライチェーン混乱
- 規制情勢
- ポーターのファイブフォース分析
- 新規参入業者の脅威
- 買い手の交渉力
- 供給企業の交渉力
- 代替品の脅威
- 競争企業間の敵対関係
第5章 市場規模と成長予測
- 用途別
- 臨床診断
- 医薬品製造QC
- 飲食品試験
- 環境モニタリング
- 化粧品試験
- 工業品質管理
- 製品別
- 計器・機器
- 試薬・消耗品
- ソフトウェア&サービス
- 技術別
- 培養ベースの検査
- 分子診断(PCR/NAAT)
- 質量分析(MALDI-TOF)
- 迅速/自動化メソッド
- バイオセンサー&ナノベースアッセイ
- エンドユーザー別
- 病院・診断研究所
- 製薬・バイオテクノロジー企業
- 飲食品企業
- CROおよびCMO
- 学術・研究機関
- 環境試験所
- 化粧品&パーソナルケア研究所
- 地域
- 北米
- 米国
- カナダ
- メキシコ
- 欧州
- ドイツ
- 英国
- フランス
- イタリア
- スペイン
- その他欧州地域
- アジア太平洋地域
- 中国
- 日本
- インド
- オーストラリア
- 韓国
- その他アジア太平洋地域
- 中東・アフリカ
- GCC
- 南アフリカ
- その他中東・アフリカ
- 南米
- ブラジル
- アルゼンチン
- その他南米
- 北米
第6章 競合情勢
- 市場集中度
- 市場シェア分析
- 企業プロファイル
- Bio-Rad Laboratories Inc.
- Abbott Laboratories
- Becton Dickinson & Company
- F. Hoffmann-La Roche Ltd
- Bruker Corporation
- Hologic Inc.
- Danaher Corp(Cepheid)
- bioMerieux SA
- Thermo Fisher Scientific Inc.
- Agilent Technologies Inc.
- Merck KGaA
- Shimadzu Corporation
- NEOGEN Corporation
- Charles River Laboratories Intl. Inc.
- QIAGEN N.V.
- Siemens Healthineers AG
- Lonza Group AG
- QuidelOrtho Corporation
- 3M Company
- Luminex Corp(DiaSorin)
- Eurofins Scientific
- Beckman Coulter MicroScan